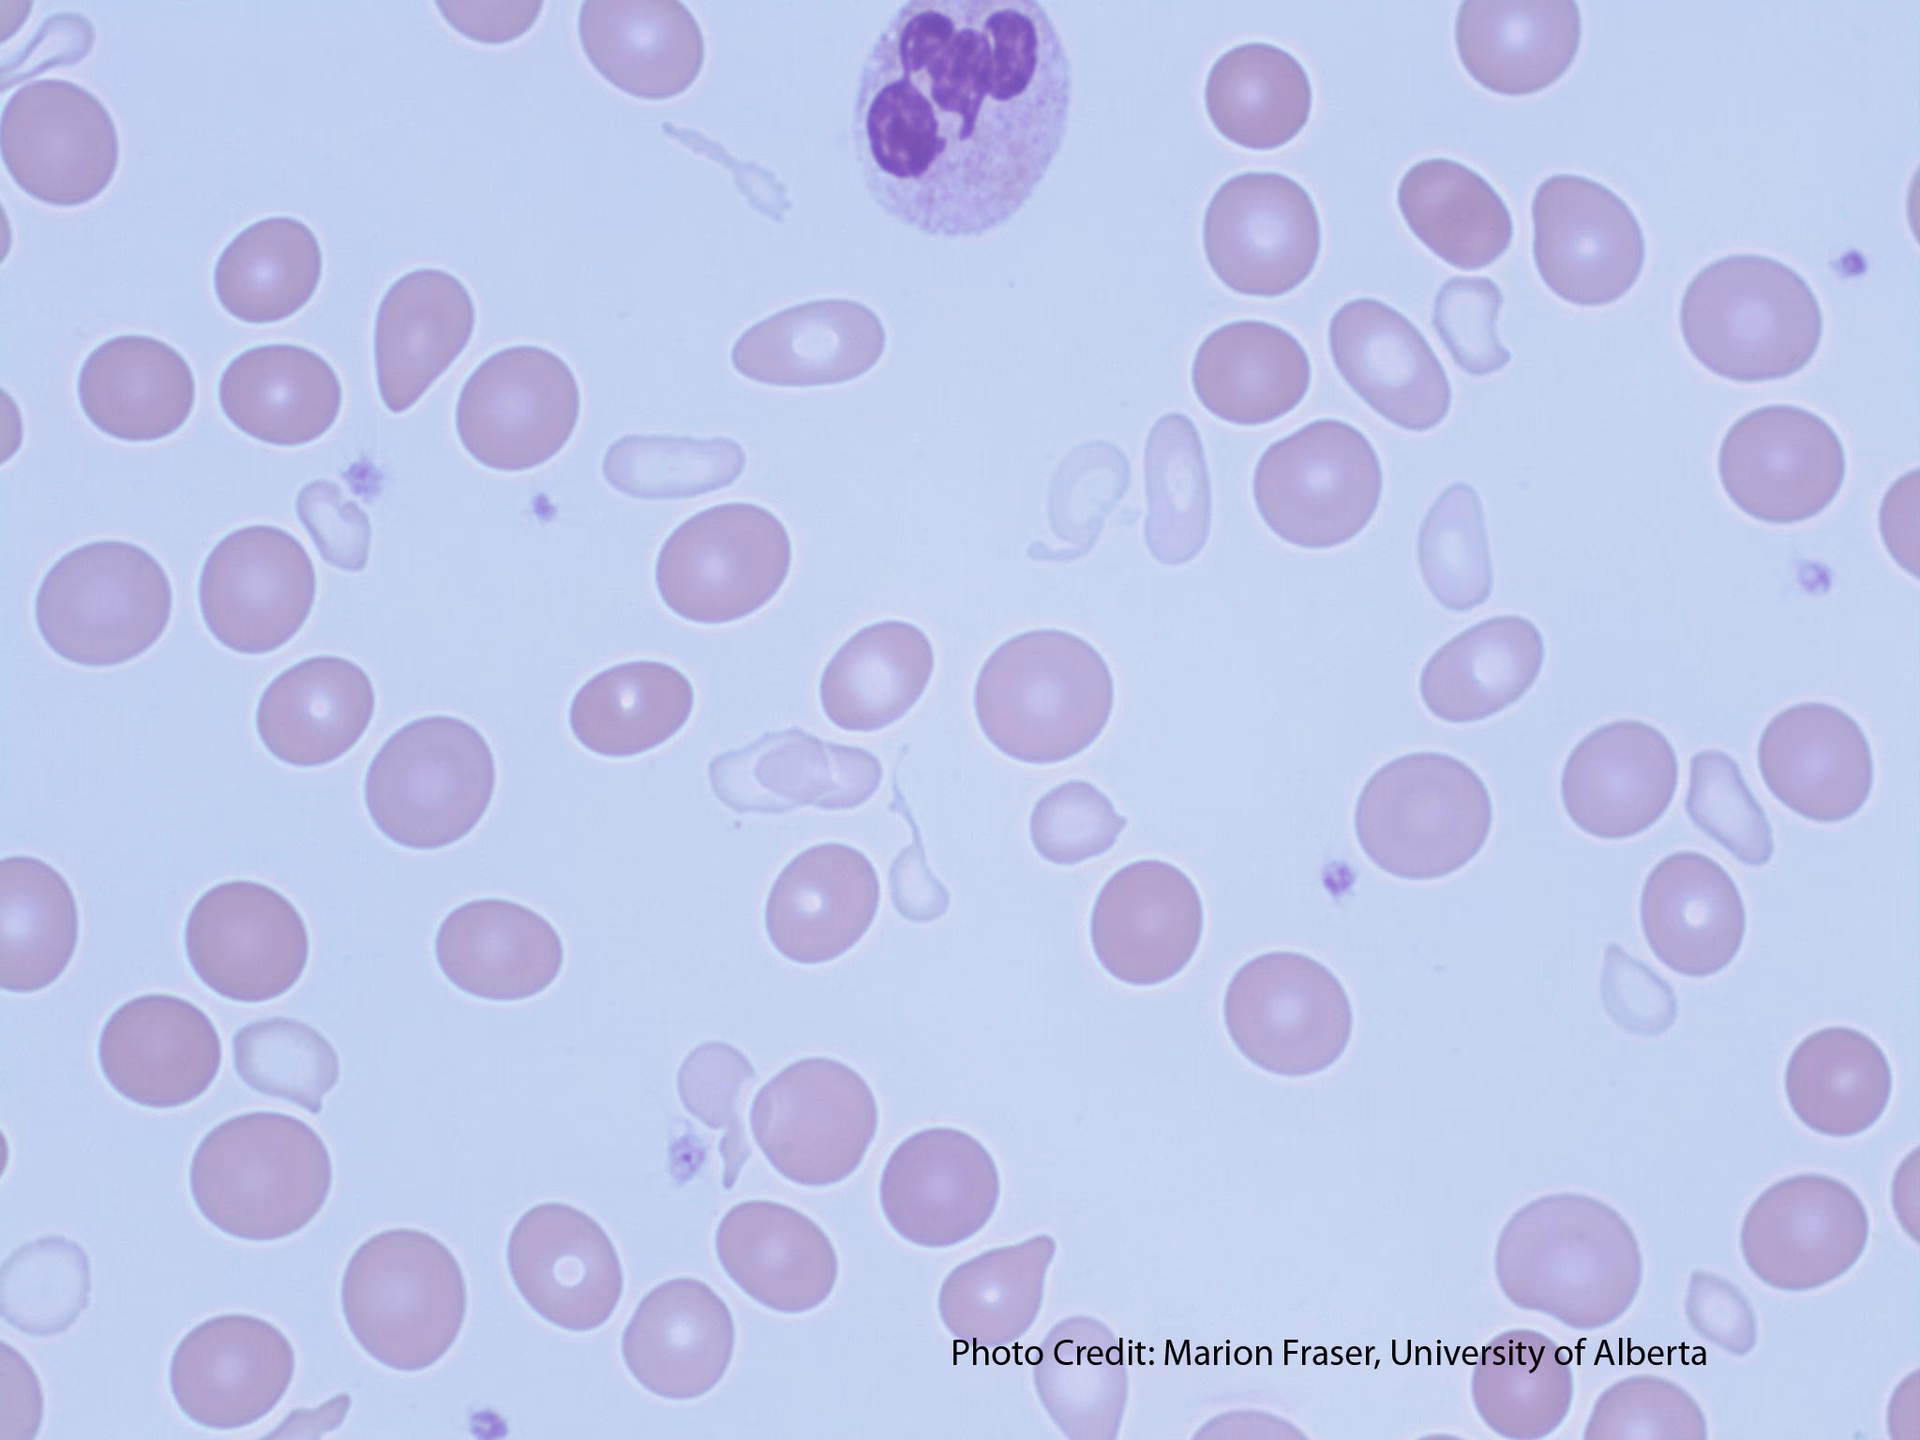
How do you know if you have sideroblastic anemia?

20/10/2003
Sideroblastisk anæmi er en gruppe af sjældne blodsygdomme, der påvirker kroppens evne til at producere sunde røde blodlegemer. Kernen i problemet er en defekt i produktionen af hæmoglobin, det protein i røde blodlegemer, der transporterer ilt. Specifikt kan kroppen ikke inkorporere jern korrekt i hæmoglobinmolekylet. Resultatet er dobbelt: en mangel på funktionelle røde blodlegemer (anæmi) og en farlig ophobning af jern i kroppens celler, især i knoglemarven. Denne artikel vil dykke ned i alle aspekter af sideroblastisk anæmi, fra de grundlæggende mekanismer til symptomer, årsager og moderne behandlingsformer.
Hvad er en Sideroblast?
For at forstå sygdommen er det vigtigt at vide, hvad en sideroblast er. Røde blodlegemer dannes ud fra forstadieceller i knoglemarven, kaldet erytroblaster. I disse celler er der små energifabrikker, mitokondrier, hvor det sidste trin i hæmoglobinproduktionen finder sted: indsættelsen af jern i et molekyle kaldet protoporfyrin for at danne hæm. Ved sideroblastisk anæmi er denne proces forstyrret. Jernet kan ikke udnyttes og begynder i stedet at hobe sig op inde i mitokondrierne.
Når en knoglemarvsprøve farves med en speciel farve (Prussian blue), der afslører jern, kan man se disse jernfyldte mitokondrier. Når de danner en ring omkring cellekernen i en erytroblast, kaldes cellen en ringsideroblast. Fundet af disse specifikke celler er et kendetegn for sideroblastisk anæmi.
Morfologisk klassificerer man sideroblaster i tre typer:
- Type 1: Færre end 5 jerngranula i cytoplasmaet.
- Type 2: 5 eller flere jerngranula, men ikke i en ring omkring kernen.
- Type 3 (Ringsideroblaster): 5 eller flere jerngranula, der omgiver mindst en tredjedel af cellekernen.
Mens type 1 og 2 kan ses ved andre tilstande, er type 3 (ringsideroblaster) det diagnostiske tegn på sideroblastisk anæmi.
Symptomer: Kroppens Advarselssignaler
Symptomerne på sideroblastisk anæmi ligner ofte dem, man ser ved andre former for anæmi, men kan også inkludere tegn på jernoverskud. De mest almindelige symptomer inkluderer:
- Ekstrem træthed og udmattelse: Mangel på ilt i kroppens væv fører til en konstant følelse af at være træt.
- Bleghed: Huden og slimhinderne kan se blege ud på grund af det lave antal røde blodlegemer.
- Svimmelhed og hovedpine: Utilstrækkelig iltforsyning til hjernen kan forårsage disse symptomer.
- Åndenød: Især ved fysisk anstrengelse, da kroppen kæmper for at få nok ilt.
- Hjertebanken: Hjertet forsøger at kompensere for den lave iltkapacitet ved at slå hurtigere.
Symptomer relateret til jernophobning (hæmokromatose) kan udvikle sig over tid og omfatter:
- Forstørret lever og milt (hepatosplenomegali): Disse organer kan blive overbelastede med jern.
- Bronze-farvet hud: Jernaflejringer i huden kan give den en karakteristisk mørk, bronzeagtig nuance.
- Organskader: Ubehandlet kan jernophobning føre til alvorlige skader på hjertet (hjertesvigt), leveren (cirrose/skrumpelever) og bugspytkirtlen (diabetes).
Årsager: Medfødt eller Erhvervet?
Sideroblastisk anæmi kan enten være en medfødt, arvelig tilstand eller en erhvervet tilstand, der udvikler sig senere i livet. Opdelingen er afgørende for både prognose og behandling.
Medfødt (Kongenital) Sideroblastisk Anæmi
Dette er sjældne, genetiske lidelser forårsaget af mutationer i gener, der er essentielle for hæmoglobinproduktionen. Den mest almindelige form er X-bundet sideroblastisk anæmi, forårsaget af en mutation i ALAS2-genet. Denne form rammer primært drenge og mænd. Andre former er autosomalt recessive, hvilket betyder, at et barn skal arve et defekt gen fra begge forældre. Nogle medfødte former er syndromiske, hvilket betyder, at anæmien optræder sammen med andre helbredsproblemer som f.eks. nedsat koordination (ataksi), muskelsvaghed eller døvhed.

Erhvervet Sideroblastisk Anæmi
Dette er den mest almindelige form og opstår typisk hos voksne. Den kan yderligere opdeles:
- Primær/Klonale former: Ofte en del af en anden knoglemarvssygdom kaldet myelodysplastisk syndrom (MDS). Her er anæmien forårsaget af en genetisk mutation i en knoglemarvsstamcelle, som f.eks. en mutation i SF3B1-genet. Denne form betragtes som en forløber for leukæmi.
- Sekundære/Reversible former: Forårsaget af en ekstern faktor. Når denne faktor fjernes, kan tilstanden forbedres eller forsvinde helt. Almindelige årsager inkluderer:
- Alkoholmisbrug: Alkohol er direkte giftigt for knoglemarven og hæmmer hæm-syntesen.
- Medicin: Visse typer medicin, især antibiotika som isoniazid (mod tuberkulose) og linezolid, kan forårsage tilstanden.
- Toksiner: Kronisk blyforgiftning er en klassisk årsag.
- Ernæringsmangler: Alvorlig mangel på kobber eller vitamin B6 (pyridoxin) kan føre til sideroblastisk anæmi, da begge er nødvendige for hæm-produktionen.
| Karakteristik | Medfødt (Kongenital) | Erhvervet |
|---|---|---|
| Debut | Barndom eller ung voksenalder | Typisk efter 50-års alderen |
| Årsag | Genetisk mutation (arvelig) | MDS, toksiner, medicin, mangeltilstande |
| Reversibilitet | Permanent, men kan behandles | Kan være reversibel, hvis årsagen fjernes |
| Risiko for leukæmi | Ingen eller meget lav | Forhøjet, især ved MDS-relaterede former |
Diagnose og Undersøgelser
Diagnosen stilles typisk af en hæmatolog (blodspecialist). Processen involverer flere trin:
- Blodprøver: En standard blodprøve vil vise tegn på anæmi. Ofte vil de røde blodlegemer være af varierende størrelse (nogle små, microcytære, og andre store, macrocytære). Jernniveauet i blodet (serumferritin) er typisk meget højt.
- Knoglemarvsundersøgelse: Den afgørende test er en knoglemarvsbiopsi. En lille prøve af knoglemarv tages, som regel fra hoftebenet, og undersøges i mikroskop. Her vil specialisten lede efter ringsideroblaster ved hjælp af Prussian blue-farvning.
- Genetisk testning: Hvis der er mistanke om en medfødt form, kan genetiske tests bekræfte specifikke mutationer.
Behandlingsmuligheder
Behandlingen afhænger fuldstændigt af den underliggende årsag og sværhedsgraden af anæmien.
Fjernelse af årsagen: For de reversible former er dette første skridt. Det kan indebære at stoppe med alkohol eller en bestemt type medicin, behandle blyforgiftning eller give tilskud af kobber eller vitamin B6.
Vitamin B6 (Pyridoxin): Høje doser af vitamin B6 kan hjælpe en betydelig del af patienter med den X-bundne medfødte form og nogle patienter med erhvervede former. Vitaminet fungerer som en co-faktor for ALAS2-enzymet og kan forbedre dets funktion.
Blodtransfusioner: For patienter med alvorlig anæmi, der giver betydelige symptomer, kan regelmæssige blodtransfusioner være nødvendige for at opretholde et acceptabelt hæmoglobinniveau og forbedre livskvaliteten.
Jernkelerende behandling: En uundgåelig konsekvens af gentagne blodtransfusioner er yderligere jernophobning. For at fjerne overskydende jern fra kroppen bruges medicin, der binder jernet og udskiller det via urin eller afføring. Dette er afgørende for at forhindre organskader.

Knoglemarvstransplantation: For yngre, egnede patienter med alvorlige former for sideroblastisk anæmi, især dem relateret til MDS med høj risiko, kan en allogen stamcelle- eller knoglemarvstransplantation være en kurativ mulighed. Dette er dog en intensiv og risikabel procedure.
Ofte Stillede Spørgsmål (FAQ)
Er sideroblastisk anæmi arveligt?
Ja, de medfødte (kongenitale) former af sygdommen er arvelige. Den mest almindelige medfødte type er X-bundet, hvilket betyder, at den primært rammer drenge og mænd og overføres fra mor til søn. De erhvervede former, som er de hyppigste, er ikke arvelige.
Kan man blive helbredt for sideroblastisk anæmi?
Det afhænger af typen. Erhvervede, reversible former kan ofte 'kureres' ved at fjerne den udløsende årsag (f.eks. stoppe med alkohol eller en bestemt medicin). Medfødte former er livslange, men symptomerne kan ofte håndteres effektivt. For visse alvorlige, erhvervede former kan en knoglemarvstransplantation tilbyde en potentiel helbredelse.
Hvad er den største risiko ved sygdommen?
De to primære risici er komplikationerne fra selve anæmien (træthed, nedsat livskvalitet) og, vigtigst af alt, de langsigtede konsekvenser af jernophobning. Ubehandlet kan jernoverskud føre til livstruende skader på hjerte, lever og andre organer. For patienter med MDS-relateret sideroblastisk anæmi er der også en øget risiko for at udvikle akut myeloid leukæmi (AML).
Er vitamin B6-behandling altid effektiv?
Nej. Behandling med høje doser af vitamin B6 (pyridoxin) er primært effektiv for patienter med den X-bundne medfødte form af sideroblastisk anæmi. Kun en mindre del af patienter med erhvervede former reagerer på behandlingen. Det er dog altid værd at forsøge, da det er en relativt simpel og sikker behandling.
Hvis du vil læse andre artikler, der ligner Sideroblastisk Anæmi: En Dybdegående Guide, kan du besøge kategorien Sundhed.
